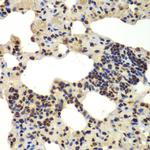
DDX5 Antibody in Immunohistochemistry (Paraffin) (IHC (P))

Search
Invitrogen
DDX5 Polyclonal Antibody
{{$productOrderCtrl.translations['antibody.pdp.commerceCard.promotion.promotions']}}
{{$productOrderCtrl.translations['antibody.pdp.commerceCard.promotion.viewpromo']}}
{{$productOrderCtrl.translations['antibody.pdp.commerceCard.promotion.promocode']}}: {{promo.promoCode}} {{promo.promoTitle}} {{promo.promoDescription}}. {{$productOrderCtrl.translations['antibody.pdp.commerceCard.promotion.learnmore']}}
图: 1 / 4
DDX5 Antibody (PA5-89140) in IHC (P)

Please note: We are reviewing Western blot images included in the antibody testing data in our catalog, including those provided by third parties. Unless expressly labeled or annotated as “raw-unedited”, Western blot images included in the antibody testing data in our catalog may have been edited, optimized or otherwise adjusted for presentation.
产品信息
PA5-89140
种属反应
宿主/亚型
分类
类型
抗原
偶联物
形式
浓度
规格
纯化类型
保存液
内含物
保存条件
运输条件
RRID
产品详细信息
Immunogen sequence: MSGYSSDRDR GRDRGFGAPR FGGSRAGPLS GKKFGNPGEK LVKKKWNLDE LPKFEKNFYQ EHPDLARRTA QEVETYRRSK EITVRGHNCP KPVLNFYEAN FPANVMDVIA RQNFTEPTAI QAQGWPVALS GLDMVGVAQT GSGKTLSYLL PAIVHINHQP FLERGDGPIC LVLAPTRELA QQVQQVAAEY CRACRLKSTC IYGGAPKGPQ IRDLERGVEI CIATPGRLID FLECGKTNLR RTTYLVLDEA DRMLDMGFEP QIRKIVDQIR PDRQTLMWSA TWPKEVRQLA EDFLKDYIHI NIGALELSAN HNILQIVDVC HDVEKDEKLI RLMEEIMSEK ENKTIVFVET KRRCDELTRK MRRDGWPAMG IHGDKSQQER DWVLNEFKHG KAPILIATDV ASRGLDVEDV KFVINYDYPN SSEDYIHRIG RTARSTKTGT AYTFFTPNNI KQVSDLISVL REANQAINPK LLQLVEDRGS GRSRGRGGMK DDRRDRYSAG KRGGFNTFRD RENYDRGYSS LLKRDFGAKT QNGVYSAANY TNGSFGSNFV SAGIQTSFRT GNPTGTYQNG YDSTQQYGSN VPNMHNGMNQ QAYAYPATAA APMIGYPMPT GYSQ; Positive Samples: HepG2, 293T, SH-SY5Y, Jurkat, Mouse brain, Rat testis; Cellular Location: Nucleus, nucleolus
靶标信息
DEAD box proteins, characterized by the conserved motif Asp-Glu-Ala-Asp (DEAD), are putative RNA helicases. They are implicated in a number of cellular processes involving alteration of RNA secondary structure, such as translation initiation, nuclear and mitochondrial splicing, and ribosome and spliceosome assembly. Based on their distribution patterns, some members of this family are believed to be involved in embryogenesis, spermatogenesis, and cellular growth and division. This gene encodes a DEAD box protein, which is a RNA-dependent ATPase, and also a proliferation-associated nuclear antigen, specifically reacting with the simian virus 40 tumor antigen. This gene consists of 13 exons, and alternatively spliced transcripts containing several intron sequences have been detected, but no isoforms encoded by these transcripts have been identified.
仅用于科研。不用于诊断过程。未经明确授权不得转售。
篇参考文献 (0)
生物信息学
蛋白别名: ATP-dependent RNA helicase DDX5; D-E-A-D (aspartate-glutamate-alanine-aspartate) box polypeptide 5; ddx5 gene protein; DEAD (Asp-Glu-Ala-Asp) box helicase 5; DEAD (Asp-Glu-Ala-Asp) box polypeptide 5; DEAD (aspartate-glutamate-alanine-aspartate) box polypeptide 5; DEAD box protein 5; DEAD box RNA helicase DEAD1; DEAD box-5; DEAD/H (Asp-Glu-Ala-Asp/His) box polypeptide 5; DEAD/H (Asp-Glu-Ala-Asp/His) box polypeptide 5 (RNA helicase, 68kD); DKFZp434E109; DKFZp686J01190; mDEAD1; MGC118083; p68 RNA helicase; Probable ATP-dependent RNA helicase DDX5; RNA helicase p68; RP23-247J12.4; unnamed protein product
基因别名: 2600009A06Rik; DDX5; G17P1; HELR; HLR1; HUMP68; p68
Entrez Gene ID: (Human) 1655, (Mouse) 13207, (Rat) 287765




